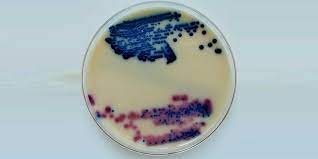
محیط کشت میلک اگار چیست

محیط کشت میلک اگار چیست
محیط کشت میلک آگار
محیط کشت میلک آگار، یکی از انواع محیط های کشت غیر انتخابی است. این نوع محیط کشت برای بررسی میکرو ارگانیسم هایی که در شیر و یا محصولات لبنی وجود دارد به کار رفته و می توان میکروارگانیسم های موجود در شیر را به راحتی شمارش کرد. شما می توانید با کلیک بر روی لینک زیر از خدمات
میلک آگار محیطی مغذی برای رشد میکروارگانیسم ها است . پس از آماده سازی، این محیط کشت می تواند با مجموعه ای از میکرو ارگانیسم ها آزمایش شده و توانایی آن ها برای هضم پروتئین کازئین، بررسی شود. کازئین یک پروتئین نامحلول و بزرگ در شیر بدون چربی است. در صورتی که میکروارگانیسم ها توانایی هضم کازئین را داشته باشند، کازئین به اسیدهای آمینه و پپتیدهای کوچک شکسته می شود. لکه های ایجاد شده بر روی سطح آگار مناطقی که کازئین شکسته شده است را نشان می دهد. محیط کشت میلک آگار یک محیط کشت نسبتا ساده و ارزان قیمت برای استفاده در آزمایشات مختلف است.
طرز تهیه محیط کشت میلک آگار
5 گرم پودر شیر خشک یا بدون چربی را به یک شیشه تمیز و خشک اضافه کنید. سپس 50 میلی لیتر آب دیونیزه به پودر شیر اضافه کرده و هم زنید. سپس در ظرفی دیگر مخلوط آب دیونیزه و آگار را اضافه کرده و در نهایت دو محلول را به هم بیافزایید. مخلوط به دست آمده به مدت 15 دقیقه در دمای 121 درجه سانتی گراد در اتوکلاو قرار داده شود. سپس محیط کشت به دست آمده را به پتری دیش منتقل کنید. قبل از استفاده زمان کافی باید داده شود تا این محیط کشت خنک و جامد شود.
- - نشانی ایمیل شما منتشر نخواهد شد.
- - لطفا دیدگاهتان تا حد امکان مربوط به مطلب باشد.
- - لطفا فارسی بنویسید.
- - میخواهید عکس خودتان کنار نظرتان باشد؟ به gravatar.com بروید و عکستان را اضافه کنید.
- - نظرات شما بعد از تایید مدیریت منتشر خواهد شد